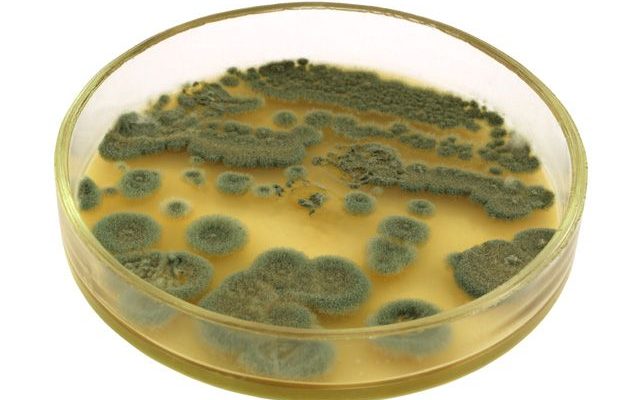

Говард Флори Эрнст Чейн
Путешествие по следам Пенициллина: Открывая тайны чудо-лекарства Мы всегда были заинтригованы историями великих открытий, особенно тех, которые изменили мир к лучшему.
Путешествие по следам Пенициллина: Как одно открытие изменило мир Мы, как и многие, часто задумываемся о том, как сильно одно-единственное открытие может
Путешествие по следам пенициллина: История‚ вдохновение и научное чудо Мы‚ как заядлые путешественники и любители науки‚
Путешествие во Времени: Как Пенициллин Изменил Мир и Что Мы Увидели, Следуя Его Следам Как часто мы задумываемся о том, как одно случайное открытие может
Путешествие в мир пенициллина: Как открытие антибиотиков изменило нашу жизнь Мы, команда энтузиастов, всегда стремились к познанию мира через путешествия.
По следам пенициллина: Путешествие в мир научных открытий Мы, как и многие, всегда восхищались гениальными открытиями, которые меняют мир.
Пенициллин: Путешествие по следам Чуда, изменившего Мир Мы, как заядлые путешественники и пытливые исследователи, всегда ищем истории, которые оставили